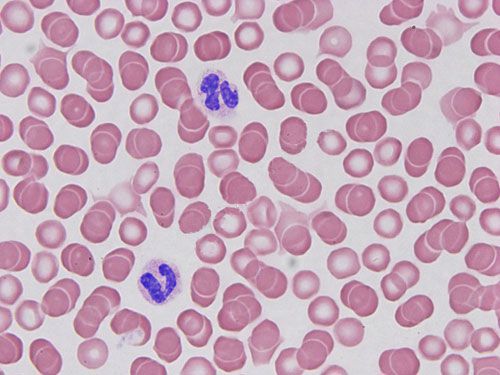
瑞氏姬姆薩染色

產品中心Cell Resources
聯系我們CONTACT US
 18225607483
18225607483
24小時服務熱線 355185756@qq.com銷售郵箱
355185756@qq.com銷售郵箱
產品詳情
用于生物染色劑,如原生質的染色,染色目的多為觀察凋亡細胞和血細胞,骨髓細胞以及受虐原蟲或幽門螺旋桿菌感染的胃腸肺肝脾等組織。實驗中多用于區分白細胞,并計數分析。
| 貨號 | 名稱 | 規格 | 價格(元) |
| PY-1066 | 瑞氏姬姆薩染色 | 張 | 30 |
實驗結果展示:
瑞氏姬姆薩染色- H 血涂片

實驗流程:
涂片-瑞氏姬姆薩染色-脫水封片-顯微鏡鏡檢
結果判讀:
涂片:紅細胞呈橘紅色圓盤狀、無細胞核;白細胞胞核呈紫紅色,染色質清楚,粗細松緊可辨;血小板為不規則細胞質小塊、周邊均勻呈淺藍色,中央為細小的紫紅色顆粒;中性粒細胞胞核呈紫藍色,顆粒呈淺紅色,形態多樣;嗜酸粒細胞胞核呈紫藍色,顆粒呈橘紅色;嗜堿粒細胞胞核呈紫藍色;淋巴細胞胞核呈藍灰色,胞質呈淡藍色;單核細胞胞核呈紫藍色,胞質呈灰藍色。
石蠟切片:紅細胞呈橘紅色圓盤狀、無細胞核,血管周邊纖維淡紅色,細胞核藍色,可見清晰核仁,肥大細胞紫紅色。
送樣運輸要求:
血涂片,肺泡灌洗液等之類涂片